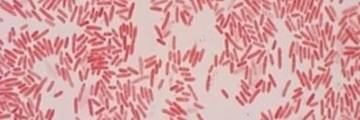
Foto para Nitro Full de AGM Fertilizer

Biofertilizante altamente concentrado 100% soluble
Nitrógeno de acción prolongada
Nitrógeno Azotobacter, Rhizobium
Reductor de acción prolongada que permite una baja volatilidad de nitrógeno

Nitro-Full es un biofertilizante versátil que da un balance constante para que pueda ser asimilado por la planta en sus formas nítrico, amoniacal y orgánico.
Es un biofertilizante altamente concentrado, 100% soluble, contiene catalizadores de tipo antioxidante, y reductor de acción prolongada que permite una baja volatilidad de nitrógeno. Cuenta con bacterias fijadores de nitrógeno Azotobacter, Rhizobium para un mejor desarrollo de la planta.
Nitro-Full está adicionado con carbono orgánico, ácidos húmicos, fúlvicos, fierro y zinc para su buen balance en nutrición.
Presentación: 5 y 20 litros
Manejo: No se transporte junto a productos alimenticios, forrajes, ropa. Manténgase fuera del alcance de los niños y animales domésticos.
Recomendaciones: No mezclar con productos que contengan calcio, y siempre hacer una prueba de compatibilidad de mezcla con el agua a utilizar y verificar el PH.
Precauciones y advertencias de uso: Aunque por la composición de este producto no es dañino para la salud, se recomienda el uso de guantes y tapa-boca durante su aplicación.
Primeros Auxilios: En caso de contacto ocular se recomienda lavar el área con agua o en caso de ingestión accidental tomar agua en abundancia.
Medidas de Protección al ambiente: Aplicar el triple lavado y entregar a los centros de acopio más cercanos.